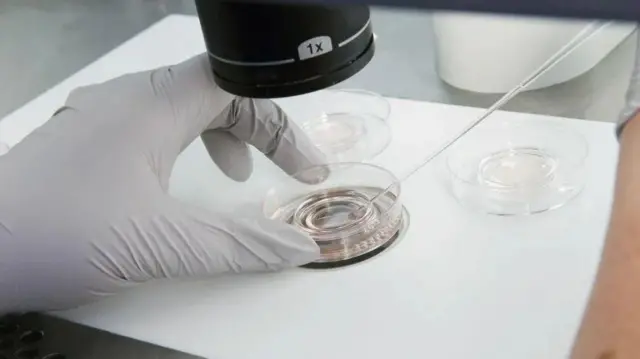
Wanawake wasio na waume hawawezi kupata ufadhili wa matibabu ya uzazi katika sehemu zote za Uingereza

'Ikiwa unataka kupata mtoto, kwa nini usubiri kupata mwanaume?'

Chanzo cha picha, HANDOUT
Idadi ya wanawake wasio na waume wanaopitia IVF au upandikizaji mbegu nchini Uingereza imeongezeka zaidi ya mara tatu katika muongo mmoja, kwa mujibu wa takwimu mpya.
Kati ya 2012 na 2022, idadi ya wanawake walio na matibabu ya uzazi ilipanda kutoka 1,400 hadi 4,800, ripoti kutoka kwa udhibiti wa uzazi inaonesha.
Wataalamu na wanawake ambao wamepanga kuwa na mzazi mmoja wanasema wanawake wengi zaidi wanaoamua kutokuwa na watoto hadi wanapokuwa wakubwa na kutopata wenzi wanaowafaa ni miongoni mwa mambo yanayochochea ongezeko hilo.
Lakini wengi bado wanakabiliwa na vikwazo vya kifedha wakati wa kupata matibabu na katika uzazi wa pekee.
Tulizungumza na akina mama, ambao waliamua kuanzisha familia yao wenyewe.
Gina, 39: 'Kuifanya kwa namna yangu kulinifaa'

Chanzo cha picha, HANDOUT
Gina alisema kwa mara ya kwanza alianza "umakini" kufikiria kuwa mama asiye na mume baada ya kufanyiwa tathmini ya uzazi katikati ya miaka yake ya 30.
Alikumbuka kwamba baada ya kupata matokeo, alijiwazia "Sawa, uzazi wangu ni mzuri kwa umri wangu ... hili ni jambo ambalo nataka kufanya".
Aliongeza: "Nilikuwa kwenye mahusiano mara kwa mara lakini nilihisi kama ni afadhali kufanya hivyo peke yangu kuliko kuwa katika uhusiano na mtu kwa muda mrefu na kufikiria ikiwa unataka kuwa na watoto naye au la, na kama wakati wako umekwisha na kama unaishia kuwa mzazi asiye na mwenzi."
Pata habari za kina kutoka BBC News Swahili, moja kwa moja kupitia WhatsApp.
Bonyeza hapa kujiunga
Mwisho wa Whatsapp
Muuguzi wa afya ya akili katika jamii alipitia upandikizaji wa ndani ya uterasi (IUI) kwa kutumia mbegu za wafadhili, matibabu ya uwezo wa kuzaa ambayo yanahusisha kuingiza mbegu moja kwa moja kwenye tumbo la uzazi wakati wa ovulation. Iligharimu takribani pauni 1,500 na alipata ujauzito mnamo 2021.
Alikuwa na mtandao wa karibu wa familia, huku dada yake akihudhuria kliniki katika uchunguzi wa jinsia, na mama yake akiwa mshirika wake wakati wa kujifungua. Alisema "hakumbuki kuwa na wasiwasi wowote" kuhusu matarajio ya mzazi mmoja.
"Kuyafanya haya kwa masharti yangu mwenyewe kulinifaa," aliongeza.
Tangu kuwa na mtoto wake wa kiume mwenye umri wa miaka miwili sasa mwaka wa 2022, amehama kutoka Yorkshire kurudi nyumbani, Northumberland ili kusaidia na shinikizo na gharama za malezi ya watoto.
"Ina wakati wake, inaweza kuwa ngumu," alikiri. "Lakini ninaendelea tu na mambo kwa sababu sina mtu mwingine wa kukatishwa tamaa".
"Ikiwa uko mahali katika maisha yako ambapo unataka kuwa na mtoto na una upendo na usaidizi karibu nawe, kwa nini ungojee mwanaume?"
Sophie, 46: 'Unabaini muda unakwenda'

Chanzo cha picha, CLAIRE LONG
Sophie alisema alitumia zaidi ya miaka yake 30 akiishi "maisha ya kufurahisha na yenye furaha", lakini hofu ya kutowahi kuwa mzazi ilianza alipokuwa akielekea miaka 40.
"Unagundua kuwa muda unakwenda na haijawa kama vile ulivyofikiria," alisema.
Aliamua kujaribu kupata mtoto peke yake, mwanzoni kupitia IUI, lakini alipoteza ujauzito.
Kisha akagandisha mayai yake na kuamua kupitia IVF peke yake. Alipokuwa na uhamisho uliofaulu wa kiinitete kilichoganda mnamo 2021, alikuwa na mpenzi wa jinsia moja ambaye ni mzazi halali wa Martha.
Lakini Sophie, ambaye alitumia takribani £30,000 katika mchakato mzima, anajiona kama "mzazi pekee".
Wakati wa ujauzito wake, na katika hatua za awali za uzazi, Sophie, alisema "hakuwahi kuwa na hofu na hakika hana majuto yoyote".
Wengine walikosoa uamuzi wake, akiwepo mshauri wake, alimwambia: "Unaleta mtoto ulimwenguni ambaye atakuwa na mzazi mmoja tu. Itakuwaje mzazi huyo akifa?"
"Niliheshimu maoni yake kabisa lakini najua sasa kwamba Martha ana umri wa miaka mitatu na tuna uhusiano wa pekee sana. Ana maisha thabiti," Sophie alisema.
Ingawa tayari amemweleza Martha jinsi alivyotungwa mimba, Sophie alisema ataendelea kuwa "wazi kuhusu kila kitu" kadiri uelewa wake unavyoongezeka.
Lakini aliongeza kuwa uzazi wa pekee aliopanga ulikuja na matatizo.
"Unafanya maamuzi yote wewe mwenyewe, unajisumbua mwenyewe, huna mtu wa kupeana naye mawazo lakini.... unatambua jinsi ulivyo na nguvu wakati mtoto anaumwa na haujapata usingizi. ," alisema.
Michelle, 42: Kuna muda wa kupata watoto - kabla ya kufika ukomo, mapenzi hayana muda
Safari ya Michelle ya kupata watoto wawili kupitia IUI kwa kutumia mtoaji mbegu za kiume ilianza baada ya kumalizika kwa uhusiano.
"Nilikuwa na mpenzi kwa muda mrefu na siku zote nilijua nilitaka kupata watoto. Alikuwa kwenye uzio kuhusu kufanya hivyo," alisema Michelle.
"Uhusiano huo ulipoisha, nilihisi 'nina umri wa miaka 38 sasa, sina wakati wa kupata mtu na kuruhusu uhusiano huo kukua kwa njia ya asili.'
Badala ya kusitasita kutafuta mtoto, Michelle aliamua kuacha kuwa na mahusiano.
Alilipa £1,800 kwa IUI kwa kutumia mtoaji mbegu na akapata mimba.
Kabla ya kujifungua mtoto wake wa kiume mnamo 2021, alikwenda kukaa na mama yake kwa muda mrefu.
"Kuna mambo mazuri na mabaya ya kuifanya na mshirika au bila," alisema.
"Kila kitu kiko kwenye mabega yako, huwezi kupata kahawa na rafiki yako bila mtoto.
Kwa upande mwingine, Michelle aliweza "kufanya maamuzi yote kuhusu majina, na wapi tutaishi na jinsi ninavyoweza kumlea," alisema.
Mnamo 2023, alipata binti kupitia njia ile ile ya kupata mimba.
Watatu hao sasa wanaishi Milton Keynes, huku watoto wakienda nyumba ya kutunza watoto siku nne kwa wiki, huku Michelle akifanya kazi siku tatu kwa wiki.
Vikwazo ni vipi?
Chanzo cha picha, Getty Images
Ingawa kumekuwa na ongezeko kubwa la idadi ya wanawake wasio na waume wanaopata matibabu ya uzazi ili kupata mimba, idadi bado ni ndogo.
Kuna vikwazo vya wazi vya kifedha kwa njia hii ya uzazi. IUI haitolewi mara kwa mara kwenye NHS, ilhali nafasi ya kufanikiwa kupata ufadhili wa IVF inategemea mahali mgonjwa anaishi nchini Uingereza.
Scotland haifadhili matibabu ya uzazi kwa wanawake wasio na waume.
Lakini katika maeneo mengi, wanawake wanapaswa kulipia angalau mizunguko sita ya upandikizaji kabla ya kukubaliwa kwa IVF inayofadhiliwa na NHS. Ndivyo ilivyo kwa Wales.
Dk Hill pia alibaini vizuizi vya kifedha vya kulea familia peke yake, na wastani wa gharama za utunzaji wa watoto za kila wiki nchini Uingereza zikipanda kwa mamia ya pauni.
"Lakini [wanawake wasio na waume wanaochagua IVF au upandikizaji ] ni mwelekeo unaokua," alisema, akiongeza kuwa wanawake ambao walitaka watoto walikuwa wanazidi kufahamu "vizuizi" vyao linapokuja suala la uzazi, na wanazidi kulichukulia suala hilo mikono mwenyewe".
Wakati huo huo, unyanyapaa umepungua, alisema Dk Hill.
"Nadhani mitazamo ya kijamii imebadilika kuhusu akina mama wasio na waume na nadhani kinachohitajika sasa ni sera kuafiki mabadiliko hayo," aliongeza.
Imetafsiriwa na Lizzy Masinga












